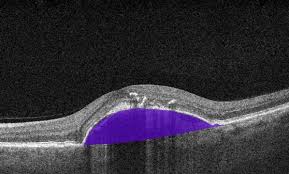

Retinal thinning- everything you need to know
The retina is a thin, light-sensitive layer located at the back of the eye. It is responsible for converting light into nerve signals that are sent to the brain, allowing us to see. A healthy retina has a normal thickness that helps maintain clear and sharp vision. Retinal thinning occurs when this layer becomes thinner than normal due to damage or loss of retinal cells, which can gradually affect vision.

Normal retinal thickness
In a healthy adult eye, the average retinal thickness measured by Optical Coherence Tomography (OCT) is approximately 250–280 micrometers in the central macula, while the peripheral retina is naturally thinner. Any significant reduction from these values is considered abnormal and may indicate retinal thinning.
Retinal thinning at early stages
Retinal thinning often develops slowly and may not cause noticeable symptoms in its early stages. As the condition progresses, patients may experience blurred vision, reduced contrast sensitivity, difficulty reading, or loss of central or side vision. Because symptoms appear late, regular eye examinations are essential for early detection.

Understanding biomechanism
The process of retinal thinning occurs when the retina does not receive enough oxygen, nutrients, or blood supply, or when nerve cells are damaged. Retinal cells such as photoreceptors and ganglion cells are highly sensitive. When these cells are injured due to disease or pressure, they begin to degenerate. Over time, this cell loss leads to a decrease in retinal thickness and structural weakness of the retina, ultimately affecting visual function.

Common causes of retinal thinning
Glaucoma
One of the most common causes of retinal thinning is glaucoma. In glaucoma, increased intraocular pressure damages the retinal nerve fiber layer and ganglion cells. As these nerve fibers slowly die, thinning occurs mainly around the optic nerve head. This type of thinning usually affects peripheral vision first and can progress silently if left untreated.

AMD
Another major cause is age-related macular degeneration (AMD). This condition affects the macula, the central part of the retina responsible for sharp vision. With aging, retinal cells become more vulnerable to oxidative stress and poor blood supply. As macular cells degenerate, central retinal thickness decreases, leading to distorted or blurred central vision and difficulty recognizing faces or reading.

Diabetes
Diabetic retinopathy is also a leading cause of retinal thinning, especially in people with long-standing diabetes. High blood sugar damages small retinal blood vessels, reducing oxygen supply to retinal tissues. Over time, chronic ischemia causes retinal cell death, resulting in thinning of various retinal layers, particularly in advanced stages of the disease.

High myopia
High myopia, especially pathological myopia, can cause retinal thinning due to excessive elongation of the eyeball. As the eye stretches, the retina becomes thin and fragile. This stretching weakens the retinal structure and increases the risk of complications such as retinal holes, tears, and detachment, especially in young adults with very high minus power.

Retinal vascular disorders
Retinal thinning can also occur due to retinal vascular disorders such as retinal vein occlusion or retinal artery occlusion. These conditions block normal blood flow to the retina, depriving retinal cells of oxygen and nutrients. The resulting damage leads to permanent loss of retinal tissue and thinning in the affected areas.
Insights
Early detection of retinal thinning is extremely important because lost retinal tissue cannot be regenerated. Tests such as OCT scans, visual field analysis, and detailed fundus examination help detect thinning at an early stage. Timely management can slow disease progression and preserve remaining vision.
Founder of EyesMatterMost- an optometry student who loves talking about eyes. I tend to cover topics related to optometry, ophthalmology, eye health, eyecare, eye cosmetics and everything in between. This website is a medium to educate my readers everything related to eyes.
